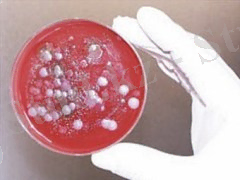
http://dolgojit.net/images/stories1/zabolevanija/sibirskaia-iazva2.jpg
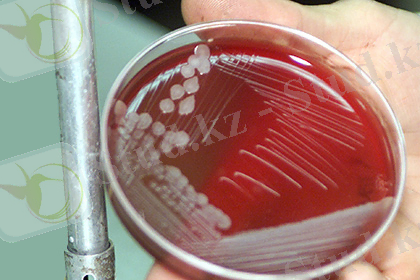
http://icdn.lenta.ru/images/2015/05/29/19/20150529190318126/pic_c6b65ec27e3bb47cff7ece85046bd2c4.jpg

Сібір жарасы мен туберкулез: адам мен жануарларда этиология, клиникалық белгілер, диагностика және алдын алу


Қазақстан Республикасы Білім және Ғылым Министірлігі Семей қаласының Шәкәрім атындағы Мемлекеттік Университеті
СӨЖ
Тақырыбы: Сібір жарасы. Туберкулез
Тексерген:Жумабеков Х. С.
Орындаған:Бахытова Г. Б.
Семей, 2015-2016
Жоспар
І. Кіріспе
ІІ. Негізгі бөлім
1. Сібір жарасы.
2. Туберкулез
ІІІ. Қорытынды
Пайдаланылған әдебиеттер
Сібір жарасы (койда - топалаң, жылқыда - жамандат, ірі карада -караталак, түйеде - ақшелек, карабез) мал және жабайы жануарлардың бациллус антрацис микробы коздыратын, жіті түрде өтетін аса қауіпті жұқпалы ауруы. Онымен адам да (түйнеме, күйдіргі) ауырады. Сібір жарасы кең тараған ауру.


А. В. Жаров және басқаларының (2003ж. ) мәліметтері бойынша, Сібір жарасы( Antnrax ) -жіті инфекциялық ауру. Ол септициямен, ішкі мүшелер мен тері астының дәнекер ұлпасының сірлі-геморрагиялық қабынуымен сипатталады. Онымен сүтқоректі жануарлардың барлығы, әсіресе бұғылар, қой, ешкілер, мүйізді ірі қара, жылқылар, сосын жабайы сиырлар мен түйелер ауырады. Шошқалар аса сезімтал емес. Сонымен қоса адам да бұл ауруға шалдығады. Иттер кейбір жыртқыш аңдар аса төзімді және сібір жарасынан өлген малдың етін жегенде қоздырғыштың организмге көп мөлшері түскенде ғана ауырады. Құстардың да бұл ауруға шалдығуы мүмкін.
Сібірде зерттеу жүргізген А. Эшке(1758ж. ) және Н. Ножевщиков (1762ж. ) бұл адам мен жануарлардың ауруына ғылыми атауын берді, ал С. С. Андриевский 1786-1788ж. ж. Уралдағы жұмысы барысында Сібір жарасымен адамның да ауыратынын және аурудың жұқпалы екендігін анықтаган. Сәл жайырақ И. Петерсан мен М. Л. Гамалея сібір жарасының қансорғыш бунақденелілер арқылы да жұғу мүмкіндігін мәлімдеген. Кейінірек Германиядағы Пеллендер(1849ж. ), Францияда Райне мен Давен (1850ж. ) індеттің өлген малдың қанынан қоздырғышын тапты. Ал Ф. Брауэль болса, 1857жылы қоздырғыштың өлексе қанымен табылуының диагностикалық маңызды екендігін анықтады. 1876жылы Р. Кох сібір жарасының таяқшасының таза культурасын бөліп алды, ал Л. Пастер 1881жылы алғаш болып қоздырғыштың әлсіз культурасымен малдарды вакцинациялау тәжірбиесін жүргізді, «Сібір жарасы» жер шарының көптеген елдерінде тіркеледі, - деп мәлімдеді.
Б. Х. Шушав (1997ж. ) сібір жарасымен адамның зақымдалуы жайында баяндайды. Жұқтыру факторларына жануар тектес инфекцияланған өнімдері, жануар тектес шикізаттар, адам дайындалған заттар, микробпен ластанған құралдар жатады. Қоздырғыш бұл кезде терідегі немесе кілегей қабаттағы микробтар арқылы ағзаға енеді. Жұғу көп жағдайда ауру малды күтіп-баққанда, сойғанда, ұманы бөлгенде, еті аспаздық өңдегенде, жануар тектес өнімдерді манипуляциялағанда, зертханаларда жұмыс режимі бұзылғанда болады. Асқорыту жолымен, трансмессивті (шыбын-шіркей шағуы арқылы) жолмен зақымдалу жағдайлары болған. Ауа, шаң-тозаң арқылы да жұғады.
Адамның тікелей қатынасында табиғи төзімділігі жоғары(жұқтыру қаупіндегі адамдардың 20%ауырады) .
Бұрынғы СССР аумағындағы елдерден Орта Азия, Қазақстан, Ресейден-Солтүстік Кавказда ауру көп таралған.
Адамдардың жоспарлық вакцинациясы жүреді. Егуге сібір жарасы қоздырғышының культурасымен, ауру зертханалық жануарлармен жұмыс істейтін, қоздырғышпен инфекцияланған материалмен жұмыс жасайтындар; зертханалық қызметкерлер, сайысқа қатысатын адамдар жатады. Вакцинациялау тірі сібір жарасының вакцинасымен жүргізіледі.
Тасымалға жіберілетін малдар тобынан ауру немесе ауруға күдіктісі табылса, барлық жануарларды тасымалға жібермей ұстап қалады. Оларды мұқият тексеріп, термометрлейді. Ауру және күдікті малды топтан бөліп алады, оларға белгіленген мөлшерде сарысу егеді, сондай-ақ симтоматикалық заттар қолданылады. Содан кейін оларды жақын жердегі ветеринарлық станцияның оқшаулағышына жібереді.
Осы партияның қалған жануарларыниммундап, карантиндейді. Ауру не күдікті мал қатынаста болған жемдерді өртейді. Бұл партиямен қатынаста болған барлық заттар дезинфекцияланады, ал құны аз құралдар жағылады. Тиитін аландар, платформалар, малды айдау алаңдары және басқа да осы топ малы тұрақтаған жерлер түгелдей дезинфекцияланады, нәжіспен қалдықтар жағылады.

В. С. Зелепукин (1987ж. ) топырақтан бөлініп алынған Bac anthracis өзгергіштігін айтады. Қазіргі кездегі сібір жарасының микробиологиясының шешілмеген мәселесі Bac anthracis сыртқы ортадағы тіршілігі мен олардың басқа биаценоз өкілдерімен экологиялық байланысы. Ұзақ жылдар бойы Bac anthracis топырақта өсіп-өнбей, тек спора түрінде сақталады деп есептелінді. Спора түзу көбею жолы болып табылмайды, керісінше қоздырғыштың тіршілігіне қолайсыз жерде сақталып қалу жолы. Бірақ та қоздырғыштың топырақта спора күйінде болуы шексіз емес. Енді анықталғандай Bac anthracis споралары топырақта белгілі бір жағдайларда вегетативті формаларға өсуі мүмкін. Қоректену шарттарына байланысты микроорганизм өз қасиеттерін өзгертеді. Олардың сапрофитті тіршілігін елестетуге болад, яғни қоздырғыш топырақта дамиды, бірақ жануар ағзасына түспейді.
Bac anthracis топырақта ұзақ уақыт болып, өсіп-өнуі оның культуралді-морфологиялық антигендік және басқа да қасиеттерінің уақыт өте келе өзгеруіне сондай -ақ вируленттіліктің жоғалуына әкеп соғады.
Топырақтың 40 жылдық мал қорымынан алтын алынған 427 сынамасын зерттегенде сібір жарасына тән 35 культура бөлініп алынған. Бірақ олардың 12 ғана тышқандарда өлім шақырған. Бұл кезде спора саны 20 млн. Топырақта дами отырып Bac anthracis тіршілік белгілерін өзгертеді. Топырақтың нақтылы жағдайына бейімделу нәтижесінде жеке экономикалық биотиптік популяциялар түзіледі. Сонымен сібір жарасы микробтарға топырақта қолайлы не қолайсыз жағдай туады.
Профилактикалық мақсатта тері астына: жылқыға, ересек мүйізді ірі қараға және бұғыларға 15-20 мл; ойға, ешкіге, бұзаулар мен шошқаларға 8-10 мл инъекциялайды. Содан кейін жануарлардың сібір жарасына төзімділігі 14 күнге сақталады.
Емдік мақсатта сарысуды сібір жарасына балау қойылғанда қолданады. Ауру малға оны тері астына мынадай мөлшерде енгізеді: жылқыға, түйеге, мүйізді ірі қараға, бұғыларға 100-200 мл; қой мен ешкіге, шошқаға 50-100 мл. Жануарларда анафилаксияны болдырмау үшін жылқыдан басқа жануарларға екінші қайтара инъекциялағанда 10-14 күннен соң ұсақ малға 0, 3-0, 5 мл, ірі қараға 1-2 мл, ал 15-30 мин откен соң толық дозасын енгізеді.
Патогенезі және клиникалық белгілері.
Жануарлардың сібір жарасымен зақымдануы алиментарлық жолмен болады, аэрогендік, жарақаттанған тері және кілегей қабаттар арқылы да болуы мүмкін. Ауру қансорғыш буынаяқтылар арқылы да жұғады. табылады. Індетке бейім келетін организмде қоздырғыш басында енген жерінде көбейеді, онда ол алдымен клеткалық, сосын жергілікті лимфа түйіндерінің тосқауылынан өтіп барып дамиды. Сібір жарасы спора түскен жерде оларға фагоциттермен, макрофагтармен ұсталады. Олардың ішінде спора күйіндегі қоздырғыш ұзаққа шыдайды. Осы клеткалардың көмегімен олар жануар ағзасының лимфа жүйесіне түсіп, сонда өсіп-дамиды. Лимфа түйіндерініңбарьерлік қызметін бұзғаннан кейін бациллдар көп мөлшерде қаннан табылады. Мал өлместен 6 сағат бұрын 84% бациллалар ұлпадан, ал өлген мезетте 72% табылады(енді олар қанда) . Әдетте мал өлер алдында жаппай септицемия көрініс табады.
Патологиялық процестің дамуы қоздырғыштың веруленттілігімен, оның капсула түзу және токсин бөліп шығару қабілеттілігімен байланысты. Сібір жарасы токсин осы аурудан өлген малдың қан плазмасынан бөлініп алынған, және де I, II, III. факторлар түрінде белгілі. Қазіргі кезде организмге әсер ету механизмі бойынша факторларісікті, қорғаушы антиген және летальді болып аталған. Сібір жарасы токсин, қантамырларының қабырғасынан өтіп, нәтежиесінде көптеген қанкетулер мен дәнекерұлпалы клетчатканың серрозы-геморрагиялық ошақтары дамиды. Аурудың терминалды сатысында токсин әсерінен гипоталамо-гипофизарлық бүйрек үсті жүйе функциясының дискоординациясы болады. Ауру малда қанның реалогиялық қасиеттері бұзылып, қан көлемінің тез төмендеуі болады. Гемоглабиннің оттегі байланыстырушы қасиетінің сақталуына қарамастан, оның қандағы мөлшері азаяды. Токсиннің бөлек, сібір жарасының қоздырғышы белсенді протеалитикалық фермент түзеді, ол ақуыздың алмасуын бұзып, ұлпалардың бұзылуына әкеледі. Осының барлығы бүйректің жетімсіздігін, орталық нерв жүйесінің бұзылуын, қышқыл-сілтілі тепе-теңдіктің төмендеуіне, қандағы мачевина азотының көбеюін тудырады.


Инкубациялық кезеңі әдетте 1-3 күнге созылып, бактерилдердің мөлшері мен вируленттілігіне, сондай-ақ организм резистенттілігіне байланысты. Аурудың өтуі өте жіті, жіті, жітілеу және созылмалы. Залалдану жолына байланысты және инфекция процесінің оқшауланған жеріне қарай аурудың терілік (карбункелезді) формасын-қоздырғыш тері арқылы енсе (жарақат, шағатын бунақденелер), антигенозды формасын тек қана шошқаларда, өкпелік-қоздырғыш тыныс алу жолдарына ауамен бірге өткенде, ішекті-инфекцияланған азық пен су қабылдағанда, антипиялық және септикалық формасын ажыратады.
Өте жіті өткенде (аноплексиялық формасы) (грек apoplexo-есінен тандырамын) ауру кенеттен басталып, ауыр өтеді. Жануарларда қозу, тіс қайырау, әрлі-берлі қозғалу, талмалар, тыныс алудың жиілеуі, тахикардия, көрінетін кілегей қабаттардың көгеруі, есінен тану, дене қызуының күрт жоғарлауы байқалады. Содан соң тепе-теңдіктің сақталуы бұзылады, ауыз бен танауынан қанды сұйықтар ағуы мүмкін, ал аналь тесігінен-қою қан аралас нәжіс бөлінеді. Малдың өлімі алғашқы симптомдар байқалғаннан 1-2сағат өткен соң болады. Егер де мал күтпеген жерден тез өлсе, онда бұны микроб токсинінің орталық нерв жүйесіне тікелей әсер етуімен байланыстырады. Мұндай жағдайда тыныс алу орталығының параличі соғады.
Аурудың апоплексиялық формасында негізгі өзгерістері бас миынан табылады. Олар мидың заты мен қабаттарының тамырының қанға толуымен және ми ұлпаларындағы қан құйылулармен сипатталады. Көп жағдайда бас миының жұмсақ қабатының сірлі-геморрагиялық қабынуы (лептоменингит) дамиды. Ондайда ми қабықшалары ісініп, нүктелік қан құйылған. Бас миынан ганглиозды клеткалардың дистрофиясы, эритроциттер арасынан лейкоциттердің табылуы байқалады. Баска мүшелердегі паталогоанатомиялық өзгерістері спецификалық емес және тек тұрып қалған қанға толулар мен дистрофиялық өзгерістер мен көрініс табады. Тері асты клетчаткасынан, қаңқа бұлшық етінен, бауыр, өкпе, ішектің сірлі қабықтарынан, құрсақтан іркілмелі гиперемия анықталады. Талағы ұлғаймаған, тек сәл домбыққан. Дара лимфа түйіндері ісінген, іркілмелі гиперемияланған, қанталаған. Өкпесі қанға толы, жіті іркілмелі ісіктермен, паренхима мен үлпершегінде геморрагияланған.
Жіті өту барысында дене қызуы 41-42С көтеріледі. Ауру малда аяқтарының әлсіздігі, қозуы мен мазасыздануы депрессиямен жалғасады. Тынысы жиілеп, ауырлайды, жүрек соғысы қатты, кілегей қабаттары цианозданған. Ауру жануар толықсып, аяқтары жансызданады және мойны қисаяды. Несептің түсі күрең-қызыл. Тәбеті қашып, күйіс қайыруы тоқтайды, өлер алдында аузы мен танауынан көбікті қен аралас сұйық ағуы мүмкін. Ауру 1-2күнге созылады.

Паталогоанатомиялық өзгерістері.
Паталогоанатомиялық өзгерістері аурудың өту барысы мен көрініс формасына байланысты. Ауру баяу өткен ғұрлым, белгілеріанық білінеді (атипиялық және созылмалы өтуін есептемегенде) . Әсіресе жіті және жітілеу формасында паталогоанатомиялық өзгерістері тән болады.
Өлексе өте үрілген, сіресуі болмайды, не әлсіз байқалады. Тек қойларда ғана мал өлгеннен бір сағат өткен соң сіресу болады және де 10-12сағат бойы сақталады. Табиғи саңылаулардан қанды көбікті сұйықтық, ал кейде қан ағады. Өлексенің іріп-шіруі, әсіресе жазғы мезгілде тез жүреді.
Тері асты клетчаткасы нүктелік георрагияланған және сарғыштанған. Оның қантамырлары қанға толы. Сондықтан сібір жаралы өлекседен сыпырылған терінің ішкі жағы күрең-қызыл түсті. Мұндай іркілімдер өкпе плеврасынан, шажырқайдан, тілден және басқа жерлерден табылады. Сірлі қабаттары қанталап, көгерген. Қаны қою-шие түсті, қою, ұйымаған.


Бұлшық еттер тас-қызыл түсті, былжыр консистенциялы. Құрсақ және кеуде қуыстарында, жүрек қабында көп мөлшерде бұлдыр қызыл түсті сұйықтық жиналған. Жүректе эпикард астында қан құйылулар табылады. Лимфа түйіндері ұлғайған, шырынды кейде беткейінде қою-шие түсті нүктелік қан кетулер болады. Олар кескінінде тас-қызыл түсті. Жалағы өте ұлғайған (кейде қалыпты), қанға толы, кескінінде жұмсарған пульпасы қара май тәріздес масса түрінде ағып шығады. Бауыр мен бөтелкелер онша ұлғаймаған. Олар тас-қызыл түсті. Ішектер гиперемияланған, толы, құрамы әдетте қан түстес болады, сұйық консистенцияланады. Аш ішек, әсіресе он екі елі ішек кілегей қабаттары гиперемияланған, ісікті және нүктелік қанталаған. Кейде ішектерде қабырғаларының қалың майлануы табылады. Пейер түйіндерінде ойық жаралар табылады. Тоқ ішектің зақымдалуы сирек кездеседі, кейде тік ішектің кілегей қабаттарында карбункулдар түрінднгі төмпешіктер байқалады.
Бас миы мен жұлын гиперемияланған, ми заты мен оның қабаттары қанталаған. Мидың жұмсақ қабығы геморрагиялық сұйықтықпен сіңірілген.
Сібір жарасының мүйізді ірі қарадағы, жылқы мен қойдағы терілік фомасы әдетте сорозды-геморрагиялық ісік түрінде өтеді, демек карбункулға тән пустулдар түзілмейді. Шошқаларда көбінесе жақасты, жұтқыншақ және мойынның лимфа түйіндерінің зақымдалуымен жалғасатын геморрагиялық лимфаденит анықталады. Мойын аумағынан жасыл түсті мұздай серозды-геморрагиялық эксудат табылады.

Зақымдалу дәрежесі мен сатысына байланысты лимфа түйінінің көлемі өзгермеуі мүмкін не болмаса тауық жұмыртқасы көлеміндей болады, көп жағдайда сарғыш түсті мұздай масса мен қоршалған. Өкпеде бұршақтан тауық жұмыртқасына дейінгі көлемдегі төмпешіктер сирегірек байқалады.
Ішектік формасында ішектердің кішкене бөлігінде геморрагиялық қабынған кілегей қабаттардың зақымдалуы түрлі интенсивті және ішектің сыртқы қабырғасының паталогоанатомиялық өзгерістеріне байланысты.
Карбункулезді формасында теріден қызыл түсті түйіндер немесе ойық жаралар табады.
Зертханалық зерттеуге сынама алу .
Ауру малдан тірі кезінде балау қою үшін(шошқадан басқа) қаны алынады (әдетте құлақтан) . Оның алынатын жерін мұқият дезинфекциялап, сосын тамырын кесіп, қанның қалың тамшысын заттық шыныға салады. Ол алдын ала залалсызданады. Айта кететін жайт, қан тамшыларын кантрафинадқа да салуға болады. Қанды алғаннан кейін тамырдан қанның шығуын тоқтатады. Қанды күре тамырдан да алуға болады. Қолданылған құралдар залалсызданады.


Көптеген зерттеушілердің есептеуінше, сібір жарасы қоздырғышын қаннан тек малдың өлуіне бірнеше сағат қалғанда ғана анықтауға болады.
Өлгеннен кейінгі балау үшін патологиялық материалды өлекседен алады. Бірақ та, қоршаған орта инфекциямен залалдау мақсатында өлексені жарып соймаған жөн. Өлген малдан да қан алады (шошқалардан басқа) . Оны құлақтан немесе басқа жердің перифериялық тамырдан алады. Мұнда қан алу әдісі жоғарыдағыдай. Егер қажетті мөлшерде қан алынбаса немесе өлексе іріпөшіріп бастаса, құлағын кесіп алады. Оны өлексе жатқан жағынан алған жөн.
Шарасыздан сойылған немесе сібір жарасына күдікті болғанда жарып-сою кезінде сақтықпен талақ, бауыр, өзгерген лимфа түйіндерінің бөліктерін алады. Шошқалардан қанды зерттеуге жіберілмейді, тек терінің кескінін, ісіктенген жерден қабынған ұлпа тілімдерін, жұтқыншақ лимфа түйіндерін алады. Алынған потологиялық материал жедел түрде зертханаға жіберіледі. Материал балауса күйінде жеткізілуі тиіс, өйткені іріп-шіріген ұлпада сібір жаралы бациллдар ериді.
Қоршаған орта обьектілерін зерттеу үшін 1л. мөлшерде шайындылар жасалады. Жүнін, түгін және қылдарын түрлі жерден алады. 2-3г мөлшерде 5 сынама.
Озықтардан сынама алу зертханаға орташа сынама жіберіледі. Ол партияның біріншілік сынамаларынан құралады; орташа сынаманың массасы 500г астам.
Судан сынаманы алу. Табиғи және жасанды суаттардан су сынамасын беткейінен алады. Әрбір сынама көлемі 0, 5л кем емес, жалпы көлемі 1л. Кем емес болуы тиіс. Су құбырынан сынама алғанда құбырды ыссы спиртті тампонмен күйдіреді.

Топырақтан сынама алу. Ол үшін зерттелетін территорияны 10-16м мөлшердегі аудандарға бөледі. Топырақтан сынама алу барысында стерилділік міндетті емес, өйткені топырақтың өзіндегі микроорганизмдер мөлшері соншалық, тіптен ауадан түсетін инфекцияның еш маңызы жоқ.
Кейбір зерттеушілердің пікірінше, топырақ сынамасын полиэтилен пакетке не ауа кірмейтін ыдысқа салу жөнсіз. Өйткені, топырақта мұндай орамда сібір жарасы қоздырғышына теріс әсер ететін актиномициттер тез дамиды.
Топырақ сынамасы алынған құралдарды дезинфекцияланады.
Балау, дифференциялдық балау .
Сібір жарасын балау қиынға соғады, әсіресе түсікпен өткенде, атипиялық көрініс тапқанда және аурудың жергілікті формаларында. Клиникалық белгілері мен паталогоанатомиялық өзгерістер әртүрлі және ондай белгілер көптеген жұқпалы және жұқпалы емес ауруларға тән келеді. Осыған байланысты тәжірбиелік жағдайларда біріншілік балау көп жағдайда дұрыс қойылмайды.
Сібір жарасына диагноз қойғанда өте мұқият болып, аурудың көрініс ерекшеліктерін ескеру қажет. Балауды эпизоотиялық мәліметтер, клиникалық белгілер, патологиялық өзгерістер мен зертханалық зерттеулер нәтежелеріне негізделініп қойылады.
Сібір жарасын балаудың негізгі әдісі-бактериологиялық. Ол үшін ауру малдан немесе өлекседен құлақ, құйрықтың қантамырларынан қан алып, заттық шыныда жуан жағындылар дайындайды. Жағындыларды ауа да кептіреді де алдымен таза қағазға, сосын полиэтилен пленкаға орап, байлайды.
Сібір жарасын кейбір жіті өтетін індеттік аурулардан ажырату қажет:мүйізді ірі қара мен қойларда-жіті пастереллезден, эмфизематозды карбункулдан, пироплазмидоздан; жылқыда-инфекциялық анемиядан, пироплазмидозадан, т. б.
Пастереллез. Бұл аурумен сібір жарасының жалпы ортақ белгілері көп, әсіресе жіті формасында. Басқа белгілерімен қатар (жоғары температура, т. б) тері асты клетчаткасында, ауыз қуысы мен жұтқыншақтың кілегей қабаты астында ісіктер табылады. Бірақ қараталаққа қарағанда пастереллез кезінде қозу мен қорқыныш күйі, болмайды, олар жітілеу формасында байқалады.
Қатерлі ісік клиникалық белгілері бойынша сібір жарасына ұқсас, бірақ та жарақатты инфекция түрінде дамиды.
Эмфизематозды карбункул кезінде ісінулері бар жерлерді сипап қарағанда крепитация естіледі, алперкуссиялағанда тимпаникалық дыбыс шығарады. Ісікті кескенде лайлы-бурыл түсті, лайдың иісі бар сұйықтық ағады, қаны күрең-қызыл, ұйыған.
Қойдың брадзоты клиникалық көріністері жағынан қараталақпен ортақ. Мал брадзотпен өлгенде, жүні тез сыпырылады. Сібір жарасында бұл байқалмайды. Сондай-ақ брадзотқа құрсақта, диафрагма мен плеврада нүктелік қан құйылулар тән. Жітілеу өткенде кілегей қабаттары сарғыш тартып, дененің кейбір жерінен жүні түседі. Сібір жарасында мұндай байқалмайды. Брадзоттан өлген малдың екі не бір бүйрегі консистенциясы ботқа тәріздес болады, талағы өзгермеген. Ал топалаңда бүйректер консистенциясы өзгермейді де, ал талағы әдетте айтарлықтай ұлғайған.
Шошқаның обасы да бұл ауруға тән белгілерге ие. Мәселен, лимфа түйіндерінің 2-3 есе ұлғаюы, қабынған, шырынды, сарғыш түсті сияқты көріністер шошқа обасына да тән. Дене қызуының жоғарылауы, кейде талақтағы инфарктілер де табылады.
Ал жылқының африкалық обасының клиникалык симптомдарын мұқият зерттегенде ғана айырмашылықтарын табуға болады. Мысалға, азық қабылдауының төмендеуі, жануар тұмсығын шелек түбіне дейін жеткізіп түсіреді, су ішкісі келеді, бірақ суы аузынан ағып кетеді. Сібір жарасында бұл көріністер орын таппайды.
Инфекциялық анемия өте жіті өткенде сібір жарасына тән көрініс береді. Аурудың жіті өтуінде жүректің жиілігі нәтежиесінен қарын аумағында іркілмей ісіктер табылады. Дамуына байланысты көздің, мұрынның, ауыздың, биелерде-қынаптың кілегей қабаттары бозғылт тартып, ісініп, майланады, жиі көптеген нүктелік қан құйылулар табылады. Сібір жарасында бұл белгілер тек жітілеу өткенде ғана байқалады.
Осыдан басқа грипп, перикардит, миокардоз, эндокарит, пироплазмоз, жүректің ұлғаюы кезінде сібір жарасына тән белгілер орын алады
Туберкулез (лат. tuberculum - төмпешік), ескіше: құрт ауру, көксау - адам мен жануарларда болатын созылмалы жұқпалы ауру.
Көп жылдар бойы іздену барысында неміс ғалымы Роберт Кох 1882 жылы туберкулездің қоздырғышын тауып, қауіпті әрі жұқпалы ауларға қарсы нақтылы күрес жүргізу ісіне баға жетпес үлес қосты. Бірнеше есе үлкейтіп микроскоппен қарағанда туберкулез микробы сәл ғана иілген таяқша сияқты болып көрінеді. Бұл аурудың қоздырғышын алғашқы кезде “ кох таяқшасы” немесе “туберкулез” таяқшасы деп атап келгенімен соңғы уақытта мұны туберкулез деп атайтын болды.
... жалғасы- Іс жүргізу
- Автоматтандыру, Техника
- Алғашқы әскери дайындық
- Астрономия
- Ауыл шаруашылығы
- Банк ісі
- Бизнесті бағалау
- Биология
- Бухгалтерлік іс
- Валеология
- Ветеринария
- География
- Геология, Геофизика, Геодезия
- Дін
- Ет, сүт, шарап өнімдері
- Жалпы тарих
- Жер кадастрі, Жылжымайтын мүлік
- Журналистика
- Информатика
- Кеден ісі
- Маркетинг
- Математика, Геометрия
- Медицина
- Мемлекеттік басқару
- Менеджмент
- Мұнай, Газ
- Мұрағат ісі
- Мәдениеттану
- ОБЖ (Основы безопасности жизнедеятельности)
- Педагогика
- Полиграфия
- Психология
- Салық
- Саясаттану
- Сақтандыру
- Сертификаттау, стандарттау
- Социология, Демография
- Спорт
- Статистика
- Тілтану, Филология
- Тарихи тұлғалар
- Тау-кен ісі
- Транспорт
- Туризм
- Физика
- Философия
- Халықаралық қатынастар
- Химия
- Экология, Қоршаған ортаны қорғау
- Экономика
- Экономикалық география
- Электротехника
- Қазақстан тарихы
- Қаржы
- Құрылыс
- Құқық, Криминалистика
- Әдебиет
- Өнер, музыка
- Өнеркәсіп, Өндіріс
Қазақ тілінде жазылған рефераттар, курстық жұмыстар, дипломдық жұмыстар бойынша біздің қор #1 болып табылады.



Ақпарат
Қосымша
Email: info@stud.kz